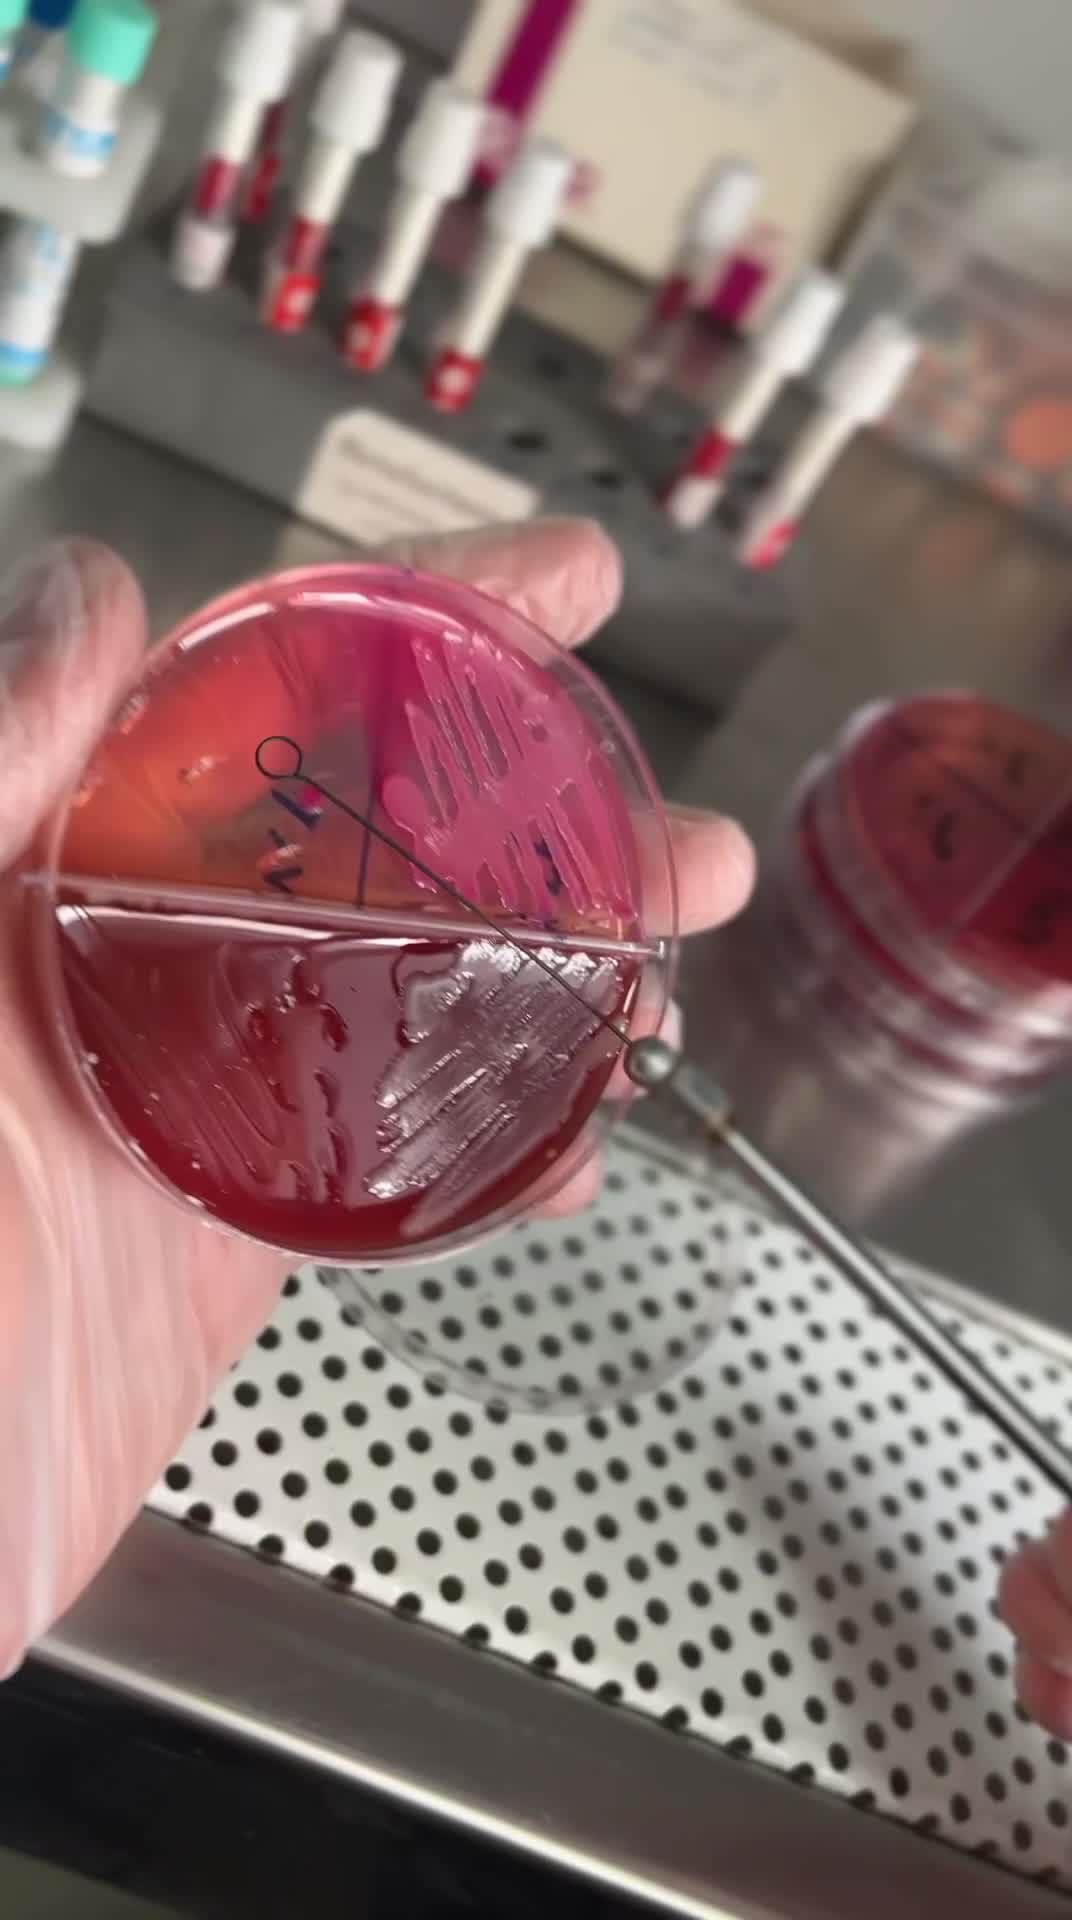
سمینار رایگان میکروبشناسی آزمایشگاه (ظرفیت محدود)|گردهمایی و همایش|تبریز, |دیوار
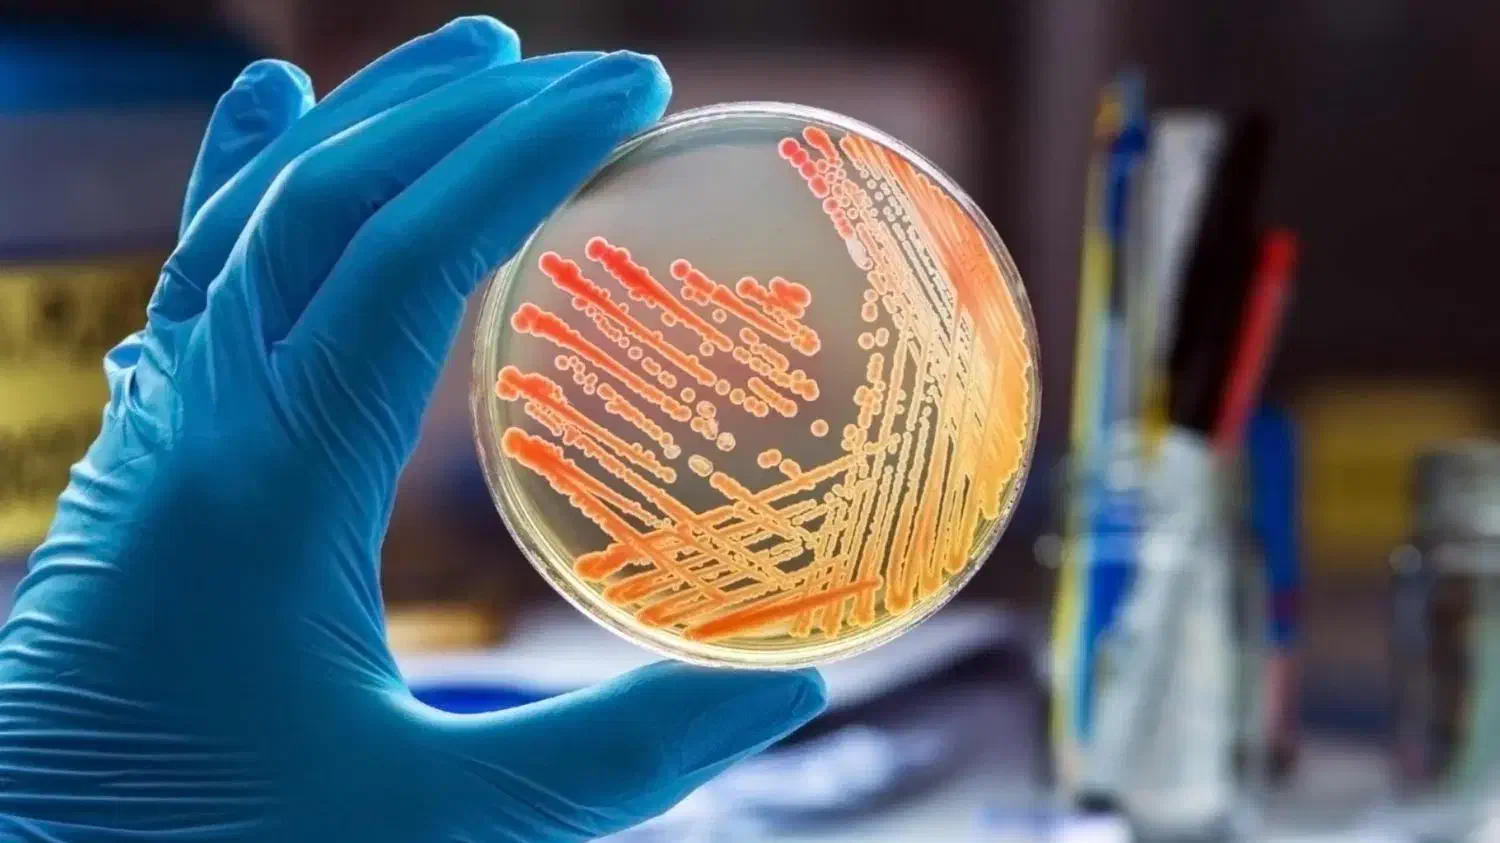
سمینار رایگان میکروبشناسی آزمایشگاه (ظرفیت محدود)|گردهمایی و همایش|تبریز, |دیوار

سمینار رایگان میکروبشناسی آزمایشگاه (ظرفیت محدود)
توضیحات
اگر قصد ورود به حوزهی آزمایشگاه تشخیصطبی را دارید یا به میکروبشناسی علاقهمند هستید، این سمینار بهترین فرصت برای آشنایی عملی با مسیر شغلی و آموزشی شماست. در این رویداد: • معرفی کامل بخشهای آزمایشگاه و فرایندهای میکروبی • آشنایی با مسیر آموزش تا استخدام تکنسین و کاربر میکروبشناسی • معرفی سرفصلهای دوره و پاسخگویی مدرس به سوالات • نکات مهم درباره ورود به بازار کار آزمایشگاهی • تخفیف ویژه ثبتنام مخصوص شرکتکنندگان زمان: دوشنبه 10 آذر، ساعت 14 محل برگزاری: شعبه پاسارگاد آپادانا – نصفراه، جنب بانک ملت حضور رایگان | ظرفیت محدود برای رزرو و دریافت اطلاعات: دایرکت در اینستاگرام: @apadana.tabriz تماس+شبکه های اجتماعی+چت دیوار رزرو سریع انجام میشود و حضور در سمینار کاملاً رایگان است. این آگهی مخصوص علاقهمندان واقعی حوزهی آزمایشگاه میباشد.
یادداشت تنها برای شما قابل دیدن است و پس از حذف آگهی، پاک خواهد شد.